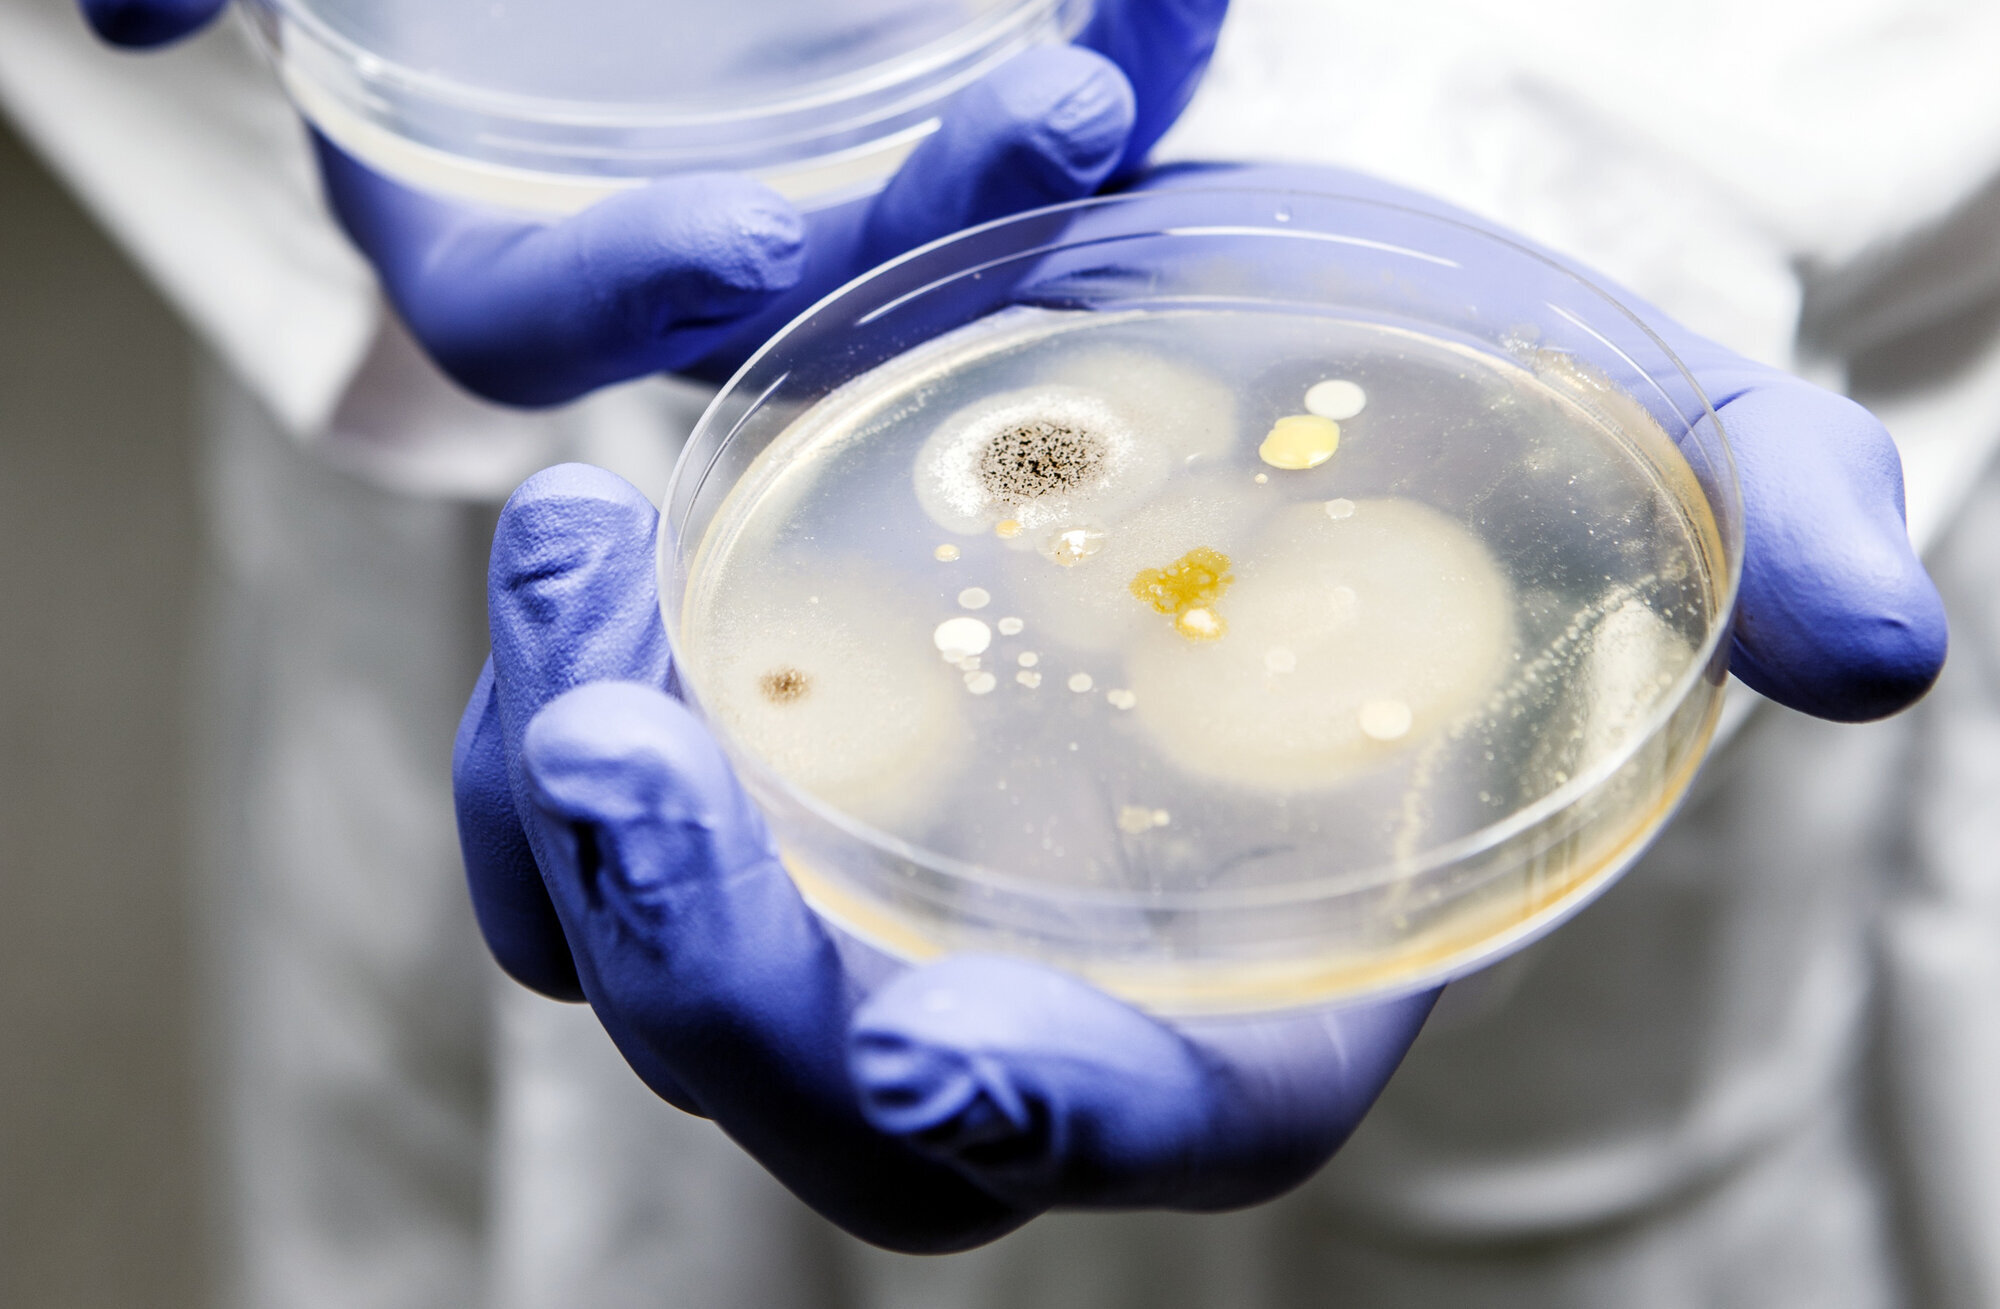
Petriskål med penicillin og bakterievekster. Bildet viser petriskål med penicillin og bakterievekster.

– Knus mytene om antibiotika
– Det finnes mange myter om antibiotika. De fleste av dem kan med fordel knuses, skriver lederen for Antibiotikasenteret for primærmedisin.
Antibiotika har helt siden oppdagelsen tidlig i forrige århundre vært myteomspunnet. På den tiden fantes det ikke mange virksomme medisiner, men man hadde lenge drømt om «den magiske kulen»: en slags geværkule man kunne skyte mot den syke, og som drepte farlige bakterier uten å skade kroppen.
Penicillinet var ganske fantastisk. Sykdommer som før hadde vært dødelige, kunne nå behandles raskt og effektivt. Men det viste seg raskt at «kulen» ikke var, tvers gjennom, magisk. Antibiotika har på sett og vis blitt et offer for sin egen suksess: Jo mer vi bruker medisinen, desto dårligere virker den.
Myter har ført til unødig og feil bruk
Magisk eller ei, virksom antibiotika er blant de viktigste ingrediensene i et velfungerende helsevesen. Men mange av mytene som har oppstått rundt medisinen, fører til unødvendig og feil bruk.
Her går vi gjennom et lite utvalg av mytene som kan være nyttig å kjenne til, og som leseren gjerne kan hjelpe til med å knuse. Et avmytologisert og realistisk syn på antibiotika i befolkningen kan bidra til en riktigere bruk – og til mindre antibiotikaresistens.
Myte nummer en
«Hvis du ikke fullfører antibiotikakuren, blir bakteriene resistente.»
Det var på sett og vis selve oppdageren av penicillinet, Alexander Fleming, som startet denne myten i sin takketale etter å ha vunnet nobelprisen i medisin i 1945. Han advarte mot resistensutvikling som følge av for lav og kortvarig penicillinbehandling.
Myten har blitt videreformidlet på både sykepleier- og medisinstudiet inntil ganske nylig. Men for de aller fleste tilstander og bakterier er det ikke sant. Det blir ikke mer resistens av å avbryte en antibiotikakur tidlig.
I arbeidet mot antibiotikaresistens prøver vi, tvert imot, å gjøre kurene stadig kortere. Et godt eksempel er streptokokkhalsinfeksjon. Tidligere har man ment at infeksjonen bør behandles med antibiotika i ti dager. Svenske kolleger har gjennomført en studie som viser at en femdagerskur mot streptokokkhalsinfeksjon er like trygt og effektivt som en tidagerskur.
En antibiotikakur skal vare akkurat lenge nok til å snu sykdomsforløpet, unngå behandlingssvikt og hindre tilbakefall. Det kan være enklere på sykehus og sykehjem enn i allmennpraksis, hvor vi ikke kan overvåke pasienten kontinuerlig. Foreløpig har vi ikke funnet ut om det er trygt å råde pasienter i allmennpraksis til å avbryte kuren når de føler seg bedre. Derfor gjør vi ikke det. Men en ting er sikkert: å avbryte kuren gir ikke mer resistens.
Myte nummer to
«Infeksjoner som skyldes bakterier, må alltid behandles med antibiotika.»
Bakterier finnes på oss og i oss i store mengder. Faktisk opptil halvannet kilo på og i et voksent menneske. Samspillet mellom kropp og bakterier går stort sett ganske greit. Vi er temmelig avhengige av bakteriene. Men av og til havner feil bakterie på feil sted og gir utgangspunkt for en infeksjon. Også det pleier å gå greit fordi kroppen har diverse motreaksjoner som bekjemper infeksjonen. Et godt eksempel er blærekatarr. Blærekatarr har plaget kvinner gjennom alle tider. Sykdommen var ikke dødelig før antibiotika kom på markedet, og er det heller ikke nå.
De aller fleste antibiotikakurer i Norge gis for å forkorte og mildne ubehagelige symptomer og ikke for å redde liv. Hvis overlevelse hadde vært eneste mål, ville de aller fleste antibiotikakurer vært unødvendige. Men så strenge trenger vi ikke å være.
Retningslinjene anbefaler antibiotika ved tilstander der nytten synes å utkonkurrere ulempene. Men grensen er ikke krystallklar, og i ulike land vurderes dette forskjellig. Uansett, ved svært mange bakterieinfeksjoner fikser kroppen selv problemet.
Myte nummer tre
«Du kan bli resistent.»
Det vil være kjent for leserne, men i befolkningen er det en utbredt oppfatning at antibiotikaresistens er noe som rammer enkeltpersoner som har brukt for mye antibiotika. Det er ikke helt uvanlig å høre pasienter argumentere for å få en antibiotikaresept fordi det er så lenge siden sist. Og at det da jo ikke kan skade. Men vi vet at det er bakterier og bakteriestammer – og ikke individer – som utvikler resistens. Og resistente bakterier trives og vinner terreng i miljøer der antibiotika brukes.
Samtidig er det noe sant i denne myten. Etter en antibiotikakur er det en økt sjanse for å bære resistente bakterier i eller på kroppen i opptil et helt år etter kuren. I tillegg er det jo slik at denne myten kan bidra til at folk unngår å ta antibiotika unødvendig av frykt for å utvikle resistens.
Konklusjonen er at denne myten knuses forsiktig.
Myte nummer fire
«Pasienter krever alltid antibiotika.»
Intervjustudier viser at pasienter med vanlige infeksjoner ofte er mer fornøyde med en grundig undersøkelse og god informasjon fremfor å få resept på antibiotika. Det erfarer også mange leger og sykepleiere.
Folks holdning til antibiotika har endret seg de siste ti til tjue årene. Det er ikke lenger slik at pasienter flest forventer antibiotika ved for eksempel ørebetennelse eller hoste. Ofte blir de lettet over å høre at de ikke trenger antibiotika.
Men fremdeles overvurderer helsepersonell pasientenes ønske om antibiotika, og det er en medvirkende årsak til unødvendig bruk. En løsning er å spørre pasienten om hva vedkommende forventer.
Myte nummer fem
«Alkohol ødelegger virkningen av antibiotika.»
Denne myten kunne kanskje fått stå i fred, for det vil uansett være smart å avstå fra store mengder alkohol når man har en infeksjon, og særlig hvis infeksjonen er såpass alvorlig at man trenger antibiotika. Men den er ikke sann.
Virkningen av antibiotika blir ikke ødelagt av alkohol. Heller ikke for metronidazol, som man tidligere mente hadde en antabus-liknende effekt. Den magiske kulen blir ikke alkoholpåvirket.
Nettsaken om alkohol og antibiotika har i årevis vært den mest leste på vår nettside antibiotika.no, så det er noe folk er opptatt av. Men om du knuser denne myten for folk, så si gjerne at de kan utsette festen til etter at de har blitt friske.








































0 Kommentarer